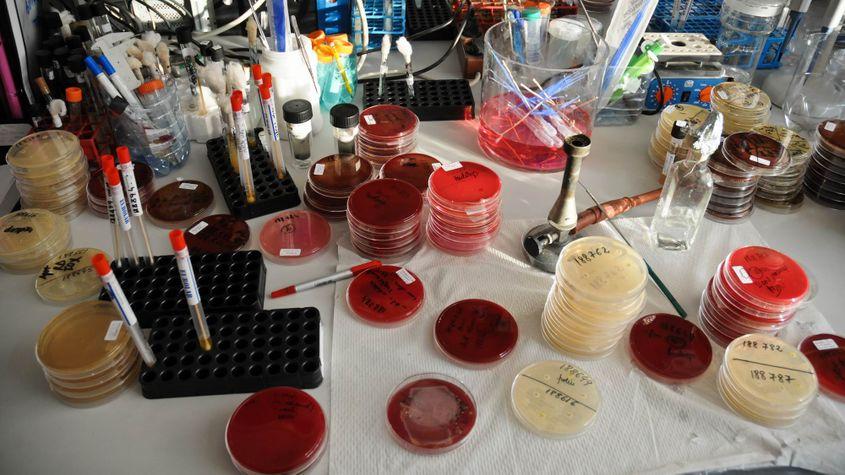

Conferenţiar universitar doctor Irina Codiţă, de la Institutul Cantacuzino. Fotografii: Lucian Muntean

Conferenţiar universitar doctor Irina Codiţă, de la Institutul Cantacuzino. Fotografii: Lucian Muntean
05/12/2015
Cum au ajuns spitalele românești focare de bacterii rezistente la antibiotice
La peste o lună de la incendiul din clubul Colectiv, medicii recunosc că o parte dintre tinerii internați cu arsuri grave au murit, de fapt, din cauza bacteriilor intraspitalicești. Rezistente la antibiotice, aceste bacterii, numite nosocomiale, le provoacă infecții fatale pacienților.
Pentru a înțelege acest fenomen, PressOne a vorbit cu șefa Departamentului de Microbiologie de Sănătate Publică din cadrul Institutului Cantacuzino, conferențiar universitar doctor Irina Codiță.
Ea spune că plăgile arse reprezintă medii perfecte de cultură pentru bacteriile nosocomiale și că majoritatea spitalelor din România nici măcar nu sunt construite astfel încât să poată limita răspândirea acestor microorganisme.
*
– Ce sunt bacteriile nosocomiale?
– De regulă, aceste bacterii sunt ubicuitare, adică se găsesc peste tot. Numai că bacteriile din spitale, din cauza faptului că pacienții sunt tratați intensiv cu antibiotice, uneori mai mult decât trebuie, sunt mai rezistente la antibiotice.
Modificările prin care devin rezistente pot surveni prin mutație, adică prin modificarea unor gene, dar și prin transfer de gene între bacteriile care circulă în anumite nișe ecologice, cum le spunem noi. Ele pot exista în spital, dar pot avea loc astfel de transferuri și în afara spitalului.
Mai exact, rezistența la antibiotice este cunoscută ca zoonoză, în sensul că unele bacterii cu rezistență la antibiotice provin din fermele de animale.
Uneori, animalele primesc antibiotice în rația de mâncare. Aceste medicamente reduc flora intestinală. Cu cât flora intestinală este mai scăzută, cu atât animalele cresc mai repede în greutate. Deci, fermierii le dau antibiotice ca factor de creștere.
S-a stabilit că există posibilitatea ca oamenii să se contamineze cu bacterii rezistente și pe această cale: fie de la fermieri sau de la cei care au contact mai apropiat cu fermele, fie chiar din produsele alimentare, mai ales dacă acestea nu sunt prelucrate termic sau dacă nu există o anumită regulă în modalitatea în care se manipulează alimentele proaspete.
Mulți ne citesc, puțini ne susțin. Fără ajutorul tău, nu putem continua să scriem astfel de articole. Cu doar 5 euro pe lună ne poți ajuta mai mult decât crezi și poți face diferența chiar acum!
– Cum ajunge un spital plin de asemenea bacterii?
– Sunt două cauze mari care conduc la persistența bacteriilor rezistente în spital.
Prima cauză este administrarea antibioticelor. Antibioticele trebuie utilizate rațional. Există niște reguli de administrare și din punct de vedere al tipului de antibiotic, și al duratei, și al dozelor.
România, din păcate, se află printre țările cu consum de antibiotice dintre cele mai mari. Oricum, în toată Europa, consumul de antibiotice este mult mai mare în fermele de animale decât la oameni. De aceea, la nivel european au fost introduse reguli care interzic utilizarea antibioticelor critice, adică cele utile și în terapia infecțiilor umane.
A doua cauză majoră este lipsa de eficiență cu care se limitează trecerea unor bacterii de la un pacient la altul sau posibilitățile de schimb genetic între bacterii. Asta ține de condițiile de spitalizare, de regulile care se aplică pentru prevenirea infecțiilor.
EXCLUSIV: Noul ministru al Agriculturii a fost ofițer “Doi ș’un sfert”
Informația, care nu apare în CV-ul noului ministru al Agriculturii, a fost confirmată pentru PressOne din surse multiple din interiorul Ministerului de Interne, care au precizat că, la un moment dat, Chesnoiu a fost ofițerul din cadrul Direcției Generale de Protecție Internă (DGPI) care s-a ocupat de supravegherea Academiei de Poliție.
Parlamentare 2016: tinerii chiulesc, rezultatul e decis de segmentul 45-64 de ani
Dezinteresul tinerilor a făcut ca rezultatul alegerilor să fie hotărât mai ales de votanții cu vârste cuprinse între 45 și 64 de ani.
– Se respectă în România regulile de igienă specifice?
– Există comitete de control al infecțiilor în toate spitalele și, în general, se aplică regulile de sterilizare, dezinfecție ș.a.m.d.
Dar în spitalele concepute după criterii moderne există posibilități de screening și de izolare a pacienților purtători. Succesul prevenirii ține mult de infrastructură.
Un newsletter pentru cititori curioși și inteligenți.
Sunt curios
Dintre bacteriile-alertă putem enumera Staphylococcus Aureus, care e rezistent la meticilină, sau bacteriile Gram-negative producătoare de carbapenemaze. Carbapenemazele sunt enzime care inactivează antibiotice dintre cele mai valoroase pentru tratamentul pacienților.
Se extind nu doar în România, ci și în țări cu posibilități mai mari de management al unităților de spital. Din punctul acesta de vedere, la nivel european există un gradient de la sud la nord și de la est la vest.
Cele mai rezistente bacterii sunt în sudul și estul Europei. Cu cât mergi mai spre nord, procentele de rezistență scad.
– Ce rămâne de făcut cu aceste spitale care nu pot oferi suficientă protecție pacienților?
– Este o problemă de infrastructură care nu se poate rezolva de pe azi pe mâine. E ușor să spui – le dăm jos, facem altele, dar nu e ușor de făcut; trebuie să păstrăm justa măsură. Soluții miraculoase nu există, dar este o problemă pentru care trebuie să colaborăm cu toții.
Chiar și atunci când nu este vorba despre arsură – unde, din start, există niște condiții extraordinar de favorabile -, infecțiile nosocomiale tot nu pot fi evitate.
Doar 30% dintre infecțiile care apar în spital pot fi evitate. Adică cele care țin de nerespectarea protocolului în ceea ce privește sterilizarea materialelor sau care se produc fiindcă există deficit de personal. Trebuie să existe un număr suficient de asistente și îngrijitoare ca să aibă timp să-și ia măsurile necesare.
Multe dintre infecții pot fi de natură endogenă. Suprafața pielii este atât de mare, încât, practic, devine un mediu de cultură. Gândiți-vă că prezintă acea serozitate care este deschisă în atmosferă și pe care se pot așeza bacterii de pe propria mea suprafață, inclusiv bacterii din conținutul intestinal.
Ce încerc să spun este că infecțiile nosocomiale nu sunt 100% culpă medicală. Dincolo de faptul că nu avem infrastructură normală și personal suficient, oricum se întâmplă.
Plaga arsă este ca un mediu de cultură viu. Noi, când cultivăm bacteriile în laborator ca să facem identificarea lor și testarea rezistenței la antibiotice, ce punem? Proteine, zaharuri, niște agenți care stabilizează pH-ul. Și le lăsăm la 37 de grade să crească. În plaga arsă am deja toate astea.
– Cum se ajunge la deces?
– Bacteriile acestea rezistente se încadrează și ele în mai multe categorii, după numărul de clase de antibiotic la care sunt rezistente. Dacă sunt rezistente la mai mult de 2-3 clase, le spunem multidrug-rezistente. Avem, după aceea, rezistență extinsă și pan-rezistență, adică nu mai reacționează la niciun antibiotic și atunci nu mai ai cum să le tratezi.
Un cercetător de marcă la nivel mondial spunea că, dacă nu reușim să controlăm puțin această problemă, ne apropiem de o situație similară perioadei pre-antibiotice. Se dau semnale în acest sens începând cu anii 1990, iar în 1998 a fost stabilit un program la nivel european.
În ultimii ani, atât Organizația Mondială a Sănătății, cât și Centrul European de Control al Bolilor Transmisibile sunt profund implicate în controlul acestei probleme de sănătate publică.
Am ajuns într-un moment în care se caută revalorificarea unor antibiotice scoase din uz la un moment dat, dar care devin necesare când cele care se utilizează în prezent nu mai funcționează.
Se caută și asocieri de antibiotice și modalități alternative de tratament în afară de antibiotice, adică atacarea microorganismului pe alte căi.
De exemplu, sunt factori care inhibă mecanismul lor de aderență. Ca să persiste în organism, o bacterie are niște sisteme cu care se prinde de piele sau de mucoase, altfel mecanismele naturale ale organismului o resping.
A existat un studiu de răsunet al englezilor asupra unor compuși pe care noi îi știm din medicina populară și pe care ei i-au găsit înscriși în nu știu ce rețetă, într-un document care data din 1500. Era vorba de asocierea usturoiului, a cepei și a mierii. Deci, ne reamintim procedee vechi, există o disperare în acest domeniu, pentru că nu mai putem să controlăm bacteriile.
– Cum să ne protejăm, totuși, de aceste bacterii rezistente?
– Nu trebuie să luăm antibiotice decât atunci când este cazul. Nu orice febră înseamnă infecție bacteriană.
Ce nu știe lumea este că antibioticele pe care le utilizăm de obicei sunt doar antibacteriene, nu și antivirale. Majoritatea acestor răceli din anotimpul rece sunt date de virusuri. Deci, nu imediat cum am răcit sau am făcut febră – să iau antibiotice, ci antiinflamatoare, ceai și băi calde la picioare.
Este și o vorbă cu viroza care, tratată, durează 14 zile, iar netratată, două săptămâni. Dacă folosim antibioticul când nu trebuie, atunci când avem cu adevărat nevoie de el nu mai acționează, pentru că deja am selectat bacterii rezistente.
*
EPILOG. Din păcate, România este fruntașă în statisticile privind răspândirea bacteriilor nosocomiale sau intraspitalicești, arată datele Centrului European de Control al Bolilor Transmisibile.
Cauza este evidențiată tot de statistici. La nivel european, România este, alături de Grecia și Franța, printre cele mai mari consumatoare de antibiotice, una dintre principalele cauze ale proliferării acestor bacterii.
Avem nevoie de ajutorul tău!
Jurnalismul independent și de serviciu public nu se face cu aer, nici cu încurajări, și mai ales nici cu bani de la partide, politicieni sau industriile care creează dependență. Se face, în primul rând, cu bani de la cititori, adică de cei care sunt informați corect, cu mari eforturi, de puținii jurnaliști corecți care au mai rămas în România.
De aceea, este vital pentru noi să fim susținuți de cititorii noștri.
Dacă ne susții cu o sumă mică pe lună sau prin redirecționarea a 3.5% din impozitul tău pe venit, noi vom putea să-ți oferim în continuare jurnalism independent, onest, care merge în profunzime.
Share this